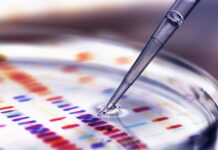
Federal government allows biotechnology companies free reign in the food system, removes safety checks on corporate science and denies transparency to farmers and food companies

More non-virus causal factors in “epidemic cases”—hospitals, by Jon Rappoport
As my long-time readers know, since 1987 in my investigations of fake epidemics, I’ve deployed the strategy of finding actual causes of illness and death that have nothing to do with the latest and greatest hype about a “new virus” creating widespread harm.
Trudeau Flounders As Florida Bans Chinese Land Purchases, by Brad Salzberg
"We don't want the CCP in the Sunshine State," says Florida Governor Ron Desantis.
Chelsea Clinton Promotes ‘The Big Catch-up’ Initiative: We Need To Stop ‘Stripping Away Public...
Millions of Americans were killed with Remdesivir and ventilators when admitted to the hospital after testing positive for Covid.
High School students who died suddenly or unexpectedly after taking COVID-19 mRNA vaccines –...
He was found dead on his bedroom floor
Shifting Narratives – Dr. Naomi Wolf joins Mark Steyn to discuss the changes in...
This morning, Ofcom found Mark Steyn and Naomi Wolf guilty of wrongthink for a discussion they had on GB News about Covid vaccine risks last October
The [DS] Corrupt System Is Being Exposed, Focus Now Shifts To [HRC] & [Renegade]...
The [DS] corrupt system is being exposed.
Trudeau Betrayal Of Freedom Of Speech Advances Communist Conversion, by Brad Salzberg
Trudeau’s internet censorship is another incremental step down the ladder to the death of democracy in Canada.
Federal government allows biotechnology companies free reign in the food system, removes safety checks...
Today, the Minister of Agriculture and Agri-Food has approved changes to Canadian Food Inspection Agency (CFIA) regulatory guidance that, along with similar changes permitted by the Minister of Health in May of 2022, allow product developers to assess the safety of their own genetically modified (GM or genetically engineered) seeds and foods without government oversight.
High School students who died suddenly or unexpectedly after taking COVID-19 mRNA vaccines –...
18 year old Trista Martin died suddenly on Nov.9, 2022 after she took Pfizer COVID-19 mRNA jab
Dr. Charles Hoffe: Natural Immunity and COVID Vaccine Health Issues | Vancouver Day 2...
His presentation sheds light on the topic and highlights the importance of exploring alternative solutions.







![The [DS] Corrupt System Is Being Exposed, Focus Now Shifts To [HRC] & [Renegade] – X22 Report](https://www.eastonspectator.com/wp-content/uploads/2023/05/monmay8thx22-218x150.jpg)